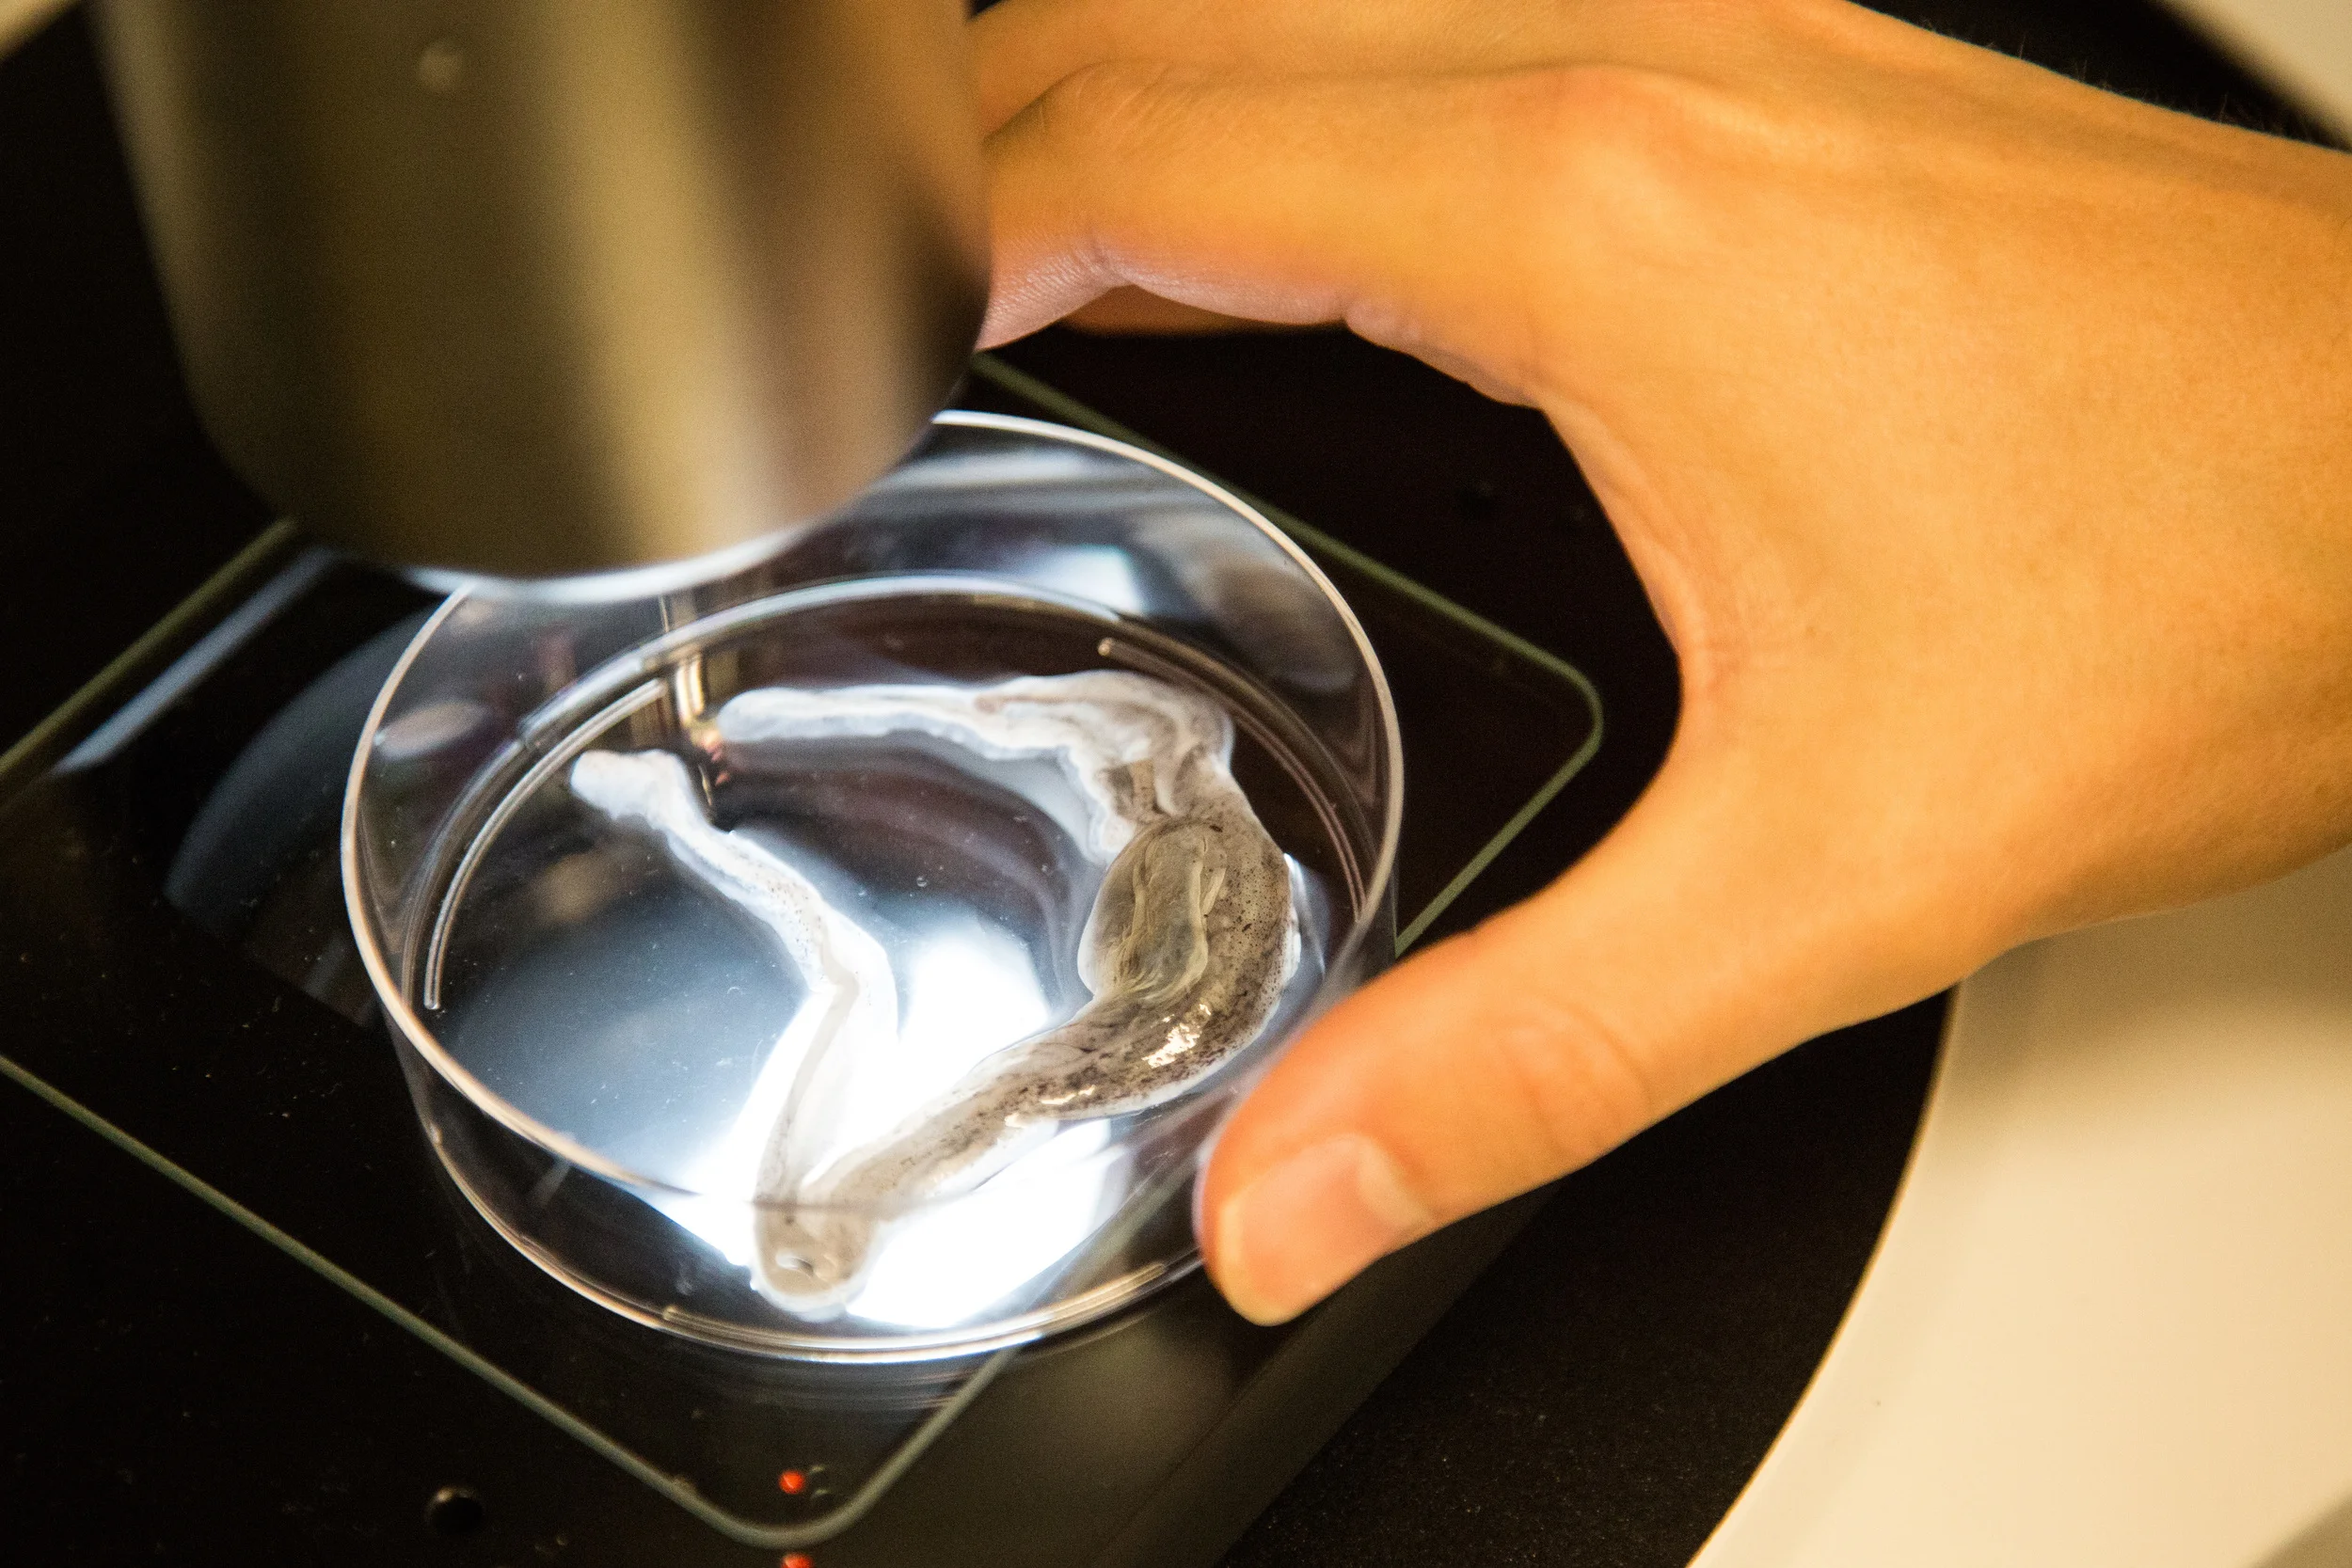

Courses
MIT MEDIA ARTS & SCIENCES (MAS) | ANCIENT FUTURE TECHNOLOGY
Since 2019, I have taught 3 editions of the MAS course Ancient Future Technology. Touching upon themes as diverse as the importance of storytelling, gifts versus commodities, reciprocity with nature, and the changing meaning of the sacred in the present world, Ancient Future Technology explores how society might begin to heal the human-nature divide through techniques and philosophies that remix traditional wisdom. Visit our webpage to learn more about the course and see examples of student projects that explore their spiritual and culture traditions as they intersect with cutting edge future technologies.
MIT MEDIA ARTS & SCIENCES (MAS) | HOW TO GROW (ALMOST) ANYTHING
In the MAS course How To Grow (Almost) Anything (HTGAA), students learn concepts and skills at the cutting edge of synthetic biology and biodesign, including DNA and protein design, machine learning, bio production, advancing imaging technologies, and other hands-on skills that can enable you to read, write, and edit organisms at the molecular scale.
We are also advancing the use of low-cost robotics to enable open- and distance-learning for our MIT and Harvard students as well as our global listener community. Learn more in our Nature Biotechnology paper and apply to join us and ‘grow almost anything’ today!
MIT MAS & SLOAN SCHOOL | SUPERMIND DESIGN FOR RESPONDING TO COVID-19
Taught by Sloan Professor Thomas W. Malone and Dr. David Sun Kong, in Supermind Design for Responding to Covid-19 in Fall 2020, students learned and applied a new methodology, called supermind design, for systematically designing innovative ways that many different kinds of groups (including governments, businesses, communities, and others) could solve problems related to the pandemic. Class sessions included instruction and practice in using the methodology as well as guest speakers and substantive material about medical, economic, political, cultural, and other aspects of the pandemic.
FAB ACADEMY | BIO ACADEMY
Together with Professor George Church of Harvard Medical School, from 2015-2017 I designed and instructed a new course for the international Fab Academy, "How To Grow Almost Anything." The Fab Academy, founded by Professor Neil Gershenfeld, houses the international course "How to Make Almost Anything." We are continuing the evolution of fab labs into bio labs. Join us today! Continue...
MIT IAP 2015 | FLUIDICS FOR SYNTHETIC BIOLOGY: PROTOTYPING MICROBIAL COMMUNITIES
The human gut is an astonishing ecosystem of trillions of micro-organisms that live in a remarkable harmony with us, the human host. In this graduate course students developed 3D design and fabrication skills and constructed fluidic, "artificial guts." Students utilized these structures to culture a variety of gut-based micro-organisms, both in mono- and co-cultures, to prototype and construct from scratch their own microbial communities. Continue...
MIT IAP 2014 | OPEN-SOURCE FLUIDICS FOR SYNTHETIC BIOLOGY
DNA assembly is the foundational technology for Synthetic Biology. In this graduate course, students developed proficiency in 3D design and fabrication technologies and constructed fluidic devices for assembling synthetic DNA. Students fabricated multi-input 3D fluidics for mixing DNA and enzyme solutions on-chip, culminating in the assembly of genetic circuits, which were booted up in bacteria and assayed for function. Continue...
MIT | DESIGN ACROSS SCALES
Biology is the future medium for design. I worked with Professor Neri Oxman of the MIT Media Lab to design and implement a 2-week module on synthetic biology as part of her course (co-taught with Professor Meejin Yoon), "Design Across Scales." More than 100 architects and designers were introduced to the latest tools and techniques for engineering biology, including a multi-day workshop on organism design, DNA assembly, and bacterial transformation. I have given an annual lecture on Designing Life from 2015-2021.
MARINE BIOLOGY LAB | PHYSIOLOGY: MODERN CELL BIOLOGY
Dating back to 1892, the Physiology Course at the Marine Biology Lab at Woods Hole is one of the longest running biology classes in the world. This legendary course was the birthplace to Nobel Prize winning experiments, in addition to boasting a lineage of instructors that includes Watson and Crick! In the summer of 2014, I was privileged to join the family at MBL and instruct a module on fluidic tools for molecular and cell biology. Continue...
UC DAVIS | INTRODUCTION TO SYNTHETIC BIOLOGY
In the Spring of 2013 I designed and taught a module on DNA assembly and microfluidics for the UC Davis undergraduate course, "Introduction to Synthetic Biology." 60 students utilized microfluidic devices to assemble genetic circuits via gateway cloning in a 4-day workshop.
student comments
"Energy, charisma, knowledge, insight, pedagogy, the complete package, boom!"
-Yaniv Turgeman, Graduate Student, Human Microbiome Center
"David's enthusiasm for the course material was nothing short of inspiring. He was also incredibly thoughtful and supportive of everyone in the class. He was able to create a community of collaborators and friends out of strangers."
-Noa Machover, Pre-Frosh
“This was by far the best class I’ve taken at MIT. I can’t believe how much I learned, and I had so much fun!”
-Che-Wei Wang, Graduate Student, Media Laboratory
“I had such a great time the last two weeks. I wish all of MIT could be more like that! We were really blown away by how much work and attention you gave to the class, it made it really special for all of us. Being able to learn things and work on projects that we couldn't do anywhere else is really why we're here.”
-Taylor Levy, Graduate Student, Media Laboratory